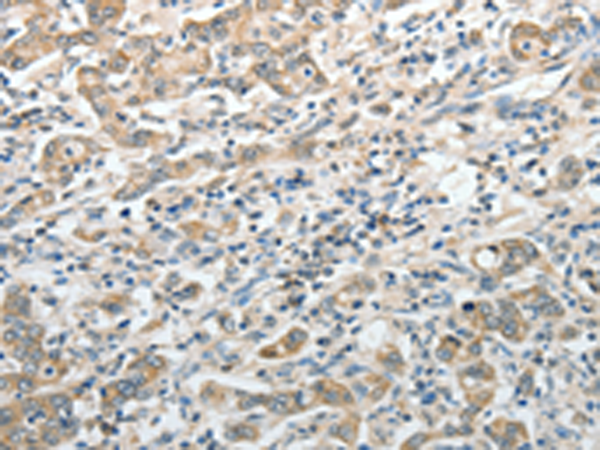

-
分类: 科研抗体货号: P07558别名: AOP1, MER5, AOP-1, SP-22, HBC189, PRO1748, prx-III应用: WB,IHC反应种属: Human, Mouse, Rat
-
分类: 科研抗体货号: P07557别名: PCP; HUMPCP应用: WB,IHC反应种属: Human, Mouse
-
分类: 科研抗体货号: P07577别名: SCR3应用: IHC反应种属: Human
-
分类: 科研抗体货号: P07556别名: HRMT1L1应用: IHC反应种属: Human
-
分类: 科研抗体货号: P07598别名: KNBC; NBC1; NBC2; pNBC; HNBC1; hhNMC; SLC4A5; NBCe1-A应用: IHC反应种属: Human, Mouse, Rat
-
分类: 科研抗体货号: P07575别名: D22S749应用: WB反应种属: Human, Mouse, Rat
-
分类: 科研抗体货号: P07590别名: SHP; SHP1应用: IHC反应种属: Human, Mouse, Rat
-
分类: 科研抗体货号: P07595别名: SIR2; SIR2L; SIR2L2应用: WB反应种属: Human, Mouse, Rat
-
分类: 科研抗体货号: P07574别名: PTPE, HPTPE, R-PTP-EPSILON应用: IHC反应种属: Human, Mouse, Rat
-
分类: 科研抗体货号: P07586别名: SGIII应用: WB,IHC反应种属: Human, Mouse, Rat

鄂公网安备42018502007531号
鄂公网安备42018502007531号

